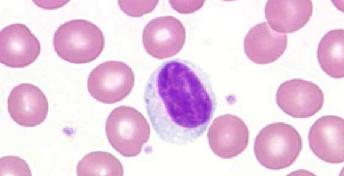

Лимфоциты — важные клеточные структуры иммунной системы, относящиеся к группе агранулоцитов. Они обеспечивают основной клеточный и гуморальный иммунитет, регулируют работу других элементов лейкоцитарного комплекса.
Лимфоциты — важные клеточные структуры иммунной системы, относящиеся к группе агранулоцитов. Они обеспечивают основной клеточный и гуморальный иммунитет, регулируют работу других элементов лейкоцитарного комплекса.
Количество таких клеточных элементов в периферической кровяной системе является важным показателем прямой оценки текущего состояния общего иммунитета человека.
Пониженный уровень лимфоцитов в крови может говорить о наличии ряда болезней, патологических состояний и индивидуальных особенностей организма пациента. В этой статье мы постараемся разобрать что это значит, и какие причины приводят к пониженному уровню лимфоцитов у детей и взрослых.
Роль лимфоцитов в организме
Ученые выделили несколько видов лимфоцитов. Каждый из них отличается способом воздействия на патогенные микроорганизмы.
- Т-лимфоциты. Данная группа является наиболее многочисленной. Она делится еще на 3 подвида. Каждый из них играет свою роль. Т-киллеры убивают инфекционных агентов, а также измененные (опухолевые клетки). Т-хелперы улучшают иммунитет, а Т-супрессоры подавляют иммунный ответ.
- В-лимфоциты. Их количество составляет 10-15 % от общей концентрации. Функции Б-лимфоцитов — одни из самых важных. Они заключаются в противостоянии вирусам, бактериям и выработке клеточного иммунитета. Именно эти вещества делают вакцинацию эффективной.
- NK-лимфоциты. Эта приставка переводится с английского как «естественные убийцы». Доля данных лейкоцитов оценивается в 5-10% от общей массы. Главная функция агентов — убивать элементы собственного организма, если они подверглись заражению.
Лимфоциты вырабатываются в костном мозге. Из крови большая часть лимфоцитов переходит в тимус (вилочковую железу), где происходит их превращение в Т-лимфоциты, защищающие организм человека от чужеродных агентов. Остальные становятся В-лимфоцитами, которые заканчивают свое формирование в лимфоидных тканях селезенки, миндалин и лимфатических узлах.
В-лимфоциты при контакте с возбудителями инфекций синтезируют антитела. Существует и третий вид лимфоцитов. Это так называемые натуральные киллеры. Они также обеспечивают защиту организма от раковых клеток и вирусов.
Норма лимфоцитов
Норма лимфоцитов: 1,2 — 3,0 тыс/мл; 25-40 %. Состояние при котором имеет место повышение количества лимфоцитов именуется лимфоцитозом, при снижении — лимфопенией.
Количественные изменения могут иметь как абсолютный характер (изменение числа на единицу объема крови), так и относительный характер — изменение процентного отношения к другим формам лейкоцитов.
Правила сдачи анализа
Количество лимфоцитов определяют при помощи клинического общего анализа крови. Чтобы результаты были достоверны, важно соблюдать следующие правила:
- Женщинам нужно сдавать анализ спустя 4–5 дней после окончания месячных;
- За 2 дня до сдачи ограничить прием соленых, жирных блюд, исключить спиртные напитки;
- За день избегать физического и эмоционального перенапряжения;
- Анализ крови сдают на голодный желудок;
- Забор проводят до 12 часов дня;
- Как минимум за 60 минут до проведения исследования нельзя курить;
- В день забора крови отказаться от приема лекарственных средств;
- Непосредственно перед забором крови нужно посидеть в спокойной обстановке на протяжении 10 минут.
Причины пониженных лимфоцитов у взрослых
Почему анализ крови выявил пониженные лимфоциты, и о чем это говорит? У взрослых людей уровень лимфоцитов в крови составляет 20-40% от всех имеющихся лейкоцитов, но при некоторых состояниях организма стандартный показатель может существенно изменятся. Очень многие причины провоцируют снижение этих клеток ввиду чего не всегда легко поставить диагноз.
К патологическим состояниям, из-за которых могут быть понижены лимфоциты у взрослых, относят:
- СПИД;
- хронические гепатологические поражения;
- апластическая анемия;
- подстадия противошока;
- септические, гнойные патологии;
- милиарный туберкулез;
- тяжелые инфекционные поражения;
- лучевая и химиотерапия;
- деструкция лимфоцитов;
- наследственные иммунные патологии;
- почечная недостаточность;
- красная волчанка (диссеминированная);
- лимфогранулематоз;
- спленомегалия;
- синдром Иценко-Кушинга;
- лимфосаркома;
- интоксикация кортикостероидами;
- острые инфекционные и гнойно-воспалительные заболевания: грипп, ангина, воспаление легких и абсцессы.
Заболевания, сопровождающиеся лимфопенией, в большинстве случаев являются весьма опасными и имеют неблагоприятный прогноз. Поэтому, если в течение длительного времени у человека диагностируются низкие лимфоциты — это сигнал к проведению немедленного и тщательного медицинского обследования.
Сама по себе лимфопения не подвергается корректировке, лечить нужно первичное заболевание. При хронической лимфоцитопении иногда назначаются инъекции иммуноглобулина. Если пониженные лимфоциты — следствие врожденного иммунодефицита, проводится трансплантация стволовых клеток.
Пониженные лимфоциты в крови у ребенка
Сниженный уровень лимфоцитов называется лимфоцитопенией (или лимфопенией). Различают два вида лимфоцитопении: абсолютную и относительную.
- Абсолютная лимфопения возникает, когда есть дефицит иммунитета (приобретенный или врожденный). Она может появиться у пациентов с лейкозом, лейкоцитозом, воздействием ионизирующей радиации, нейтрофилезом.
- При относительной лимфопении нарушается развитие лимфоидной системы, тогда лимфоциты гибнут очень ускоренно. Возникает она и как следствие хронических инфекций и острых инфекционных заболеваний.
Лимфопения у ребенка не проявляется никакими видимыми симптомами. Но в связи с клеточным иммунодефицитом могут проявляться такие признаки как:
- значительное уменьшение лимфоузлов и миндалин;
- экзема, пиодермия (гнойное поражение кожи);
- алопеция (выпадение волос);
- спленомегалия (увеличение селезенки);
- желтушность, бледность кожи;
- петехии (геморрагические пятна на коже).
Если лимфоциты понижены в крови, у ребенка часто происходят рецидивы инфекционных заболеваний, а в качестве возбудителей нередко выступают редкие виды микроорганизмов.
Возможные симптомы
Обычно лимфопения протекает бессимптомно, то есть без ярко выраженных признаков. Однако среди возможных симптомов низкого уровня лимфоцитов следует выделить такие признаки:
- Увеличение селезенки.
- Общая слабость.
- Гнойное поражении кожных покровов.
- Частая усталость.
- Бледность кожных покровов или их желтушность.
- Уменьшение лимфатических узлов и миндалин.
- Выпадение волос.
- Возникновение экземы и высыпаний на коже.
- Часто симптомом пониженного показателя лимфоцитов является повышение температуры тела.
При возникновении этих признаков желательно сдать анализ, чтобы проверить не сопровождают ли они лимфопению, которая может свидетельствовать о различных инфекционно-воспалительных процессах в человеческом организме.
Что делать, если лимфоциты в крови понижены
Специфического лечения пониженных лимфоцитов не существует, поскольку симптом может вызываться целым рядом тяжелых патологий, а также индивидуальными физическими особенностями.
При обнаружении и подтверждении лабораторных результатов пониженного уровня лимфоцитов в крови, а также отсутствия четкой симптоматики причины его формирования, врач-гематолог направляет пациента на дополнительную диагностику — ультразвуковое исследование, МРТ/КТ, рентгенографию, гистологию, цитологию и так далее.
Для взрослых и детей, курс терапии назначается исключительно на основании выявленного диагноза с учётом индивидуальных особенностей организма больного и его возраста.

